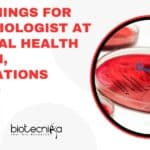
40 Openings For Microbiologist at National Health Mission, Applications Invited National Health Mission Microbiologists

Home Search
microbiology - search results
If you're not happy with the results, please do another search
40 Openings For Microbiologist at National Health Mission, Applications Invited
National Health Mission Microbiologists - 40 Vacancies Available
National Health Mission Microbiologists - 40 Vacancies Available. National Health Mission jobs. MSc Microbiology job openings. National...
ICMR-NIRRCH Project Scientist Job In Project Involving Bioinformatics & Comp Bio, Apply Online
ICMR-NIRRCH Project Scientist Job In Project Involving Bioinformatics & Comp Bio, Apply Online
ICMR-NIRRCH Project Scientist Job In Project Involving Bioinformatics & Comp Bio, Apply...
ICMR-NIRRCH Bioinformatics, Biotech, Life Sciences SRF Job Opening, Apply Online
ICMR-NIRRCH Bioinformatics, Biotech, Life Sciences SRF Job Opening, Apply Online
ICMR-NIRRCH Bioinformatics, Biotech, Life Sciences SRF Job Opening, Apply Online. NIRRH recruitment for SRF Job....
CSIR-IMTECH Microbial Analysis Project Associate Recruitment, Attend Walk-In
IMTECH Vacancy 2023 For Agricultural Sciences Candidates, Attend Walk-In
IMTECH Vacancy 2023 For Agricultural Sciences Candidates, Attend Walk-In. MSc Natural and Agricultural Sciences Project job....
Biotecnika Times Newsletter 02.03.2023 Short-term Training 2023, NBRC Admission, CIAB Fellowships
Biotecnika Times Newsletter 02.03.2023 Short-term Training 2023, NBRC Admission, CIAB Fellowships
Short-Term Training 2023 For Biological Sciences Candidates at Bose Institute, Apply Online
Short-Term Training 2023...
GATE Biotechnology Formula Sheet PDF Download For Last Minute Revision
GATE Biotechnology Formula Sheet
Graduate Aptitude Test in Engineering, commonly known as GATE, is a national-level examination that tests the aptitude of engineering and science...
CIAB Fellowships 2023 For MSc, MTech & PhD Life Sciences Candidates, Attend Walk-In
CIAB Fellowships 2023 For MSc, MTech & PhD Life Sciences Candidates, Attend Walk-In
CIAB Fellowships 2023 For MSc, MTech & PhD Life Sciences Candidates, Attend...
Biotecnika Times Newsletter 01.03.2023 CSIR-CCMB, IGIB PhD Admission 2023 Notification, Whole Genome Sequencing Workshop
Biotecnika Times Newsletter 01.03.2023 CSIR-CCMB, IGIB PhD Admission 2023 Notification, Whole Genome Sequencing Workshop
CSIR-CCMB August 2023 PhD Program Admission - Online Application Process
CCMB 2023...
CSIR-IGIB PhD Program 2023 – Online Application Process
CSIR-IGIB PhD Program 2023 - Online Application Process
CSIR-IGIB PhD Program 2023 - Online Application Process. CSIR-IGIB PhD Program 2023 - Online Application Process PhD...
Biotecnika Times Newsletter 28.02.2023 NEST Registrations Open, Govt NIB Hiring, CFTRI Admissions 2023, NABI...
Biotecnika Times Newsletter 28.02.2023 NEST Registrations Open, Govt NIB Hiring, CFTRI Admissions 2023, NABI Multiple Project Jobs
NEST 2023: National Entrance Screening Test Registrations Open!
National...
NABI Project Vacancies 2023 For MSc, MTech & PhD In Multiple Projects, Attend Walk-In
NABI Research Jobs 2023 For Life Sciences, Attend Walk-In
NABI Research Jobs 2023 For Life Sciences, Attend Walk-In. NABI Research Jobs 2023. NABI Research Jobs...
CSIR-CFTRI Admission – PhD Under University of Mysore (August 2023)
CFTRI Admission 2023 August – PhD Under University of Mysore
CSIR-CFTRI Ph.D. ADMISSION (August 2023)
Ph.D. under University of Mysore
CSIR-CFTRI is a recognized organization for doing...
Biotecnika Times Newsletter 27.02.2023 FSSAI Internship With Stipend, IITGN Summer Research Internship
Biotecnika Times Newsletter 27.02.2023 FSSAI Internship With Stipend, IITGN Summer Research Internship
FSSAI Internship Scheme For April 2023 With Rs. 10,000 Stipend, Apply Online
FSSAI Internship...
FSSAI Internship Scheme For April 2023 With Rs. 10,000 Stipend, Apply Online
FSSAI Internship 2023 April Scheme, Apply Online
FSSAI Internship 2023 April Scheme, Apply Online. Food Safety and Standards Authority of India Internship 2023. Internship Scheme...
University of Calcutta JRF Post Available For MSc Biochem/Microbio/Biophysics & Mol Bio/Biotech
Calcutta University Job Opening 2023 For MSc Biotech, Biophysics, Mol Bio, Microbiology, Biochem
Calcutta University Job Opening 2023 For MSc Biotech, Biophysics, Mol Bio, Microbiology,...